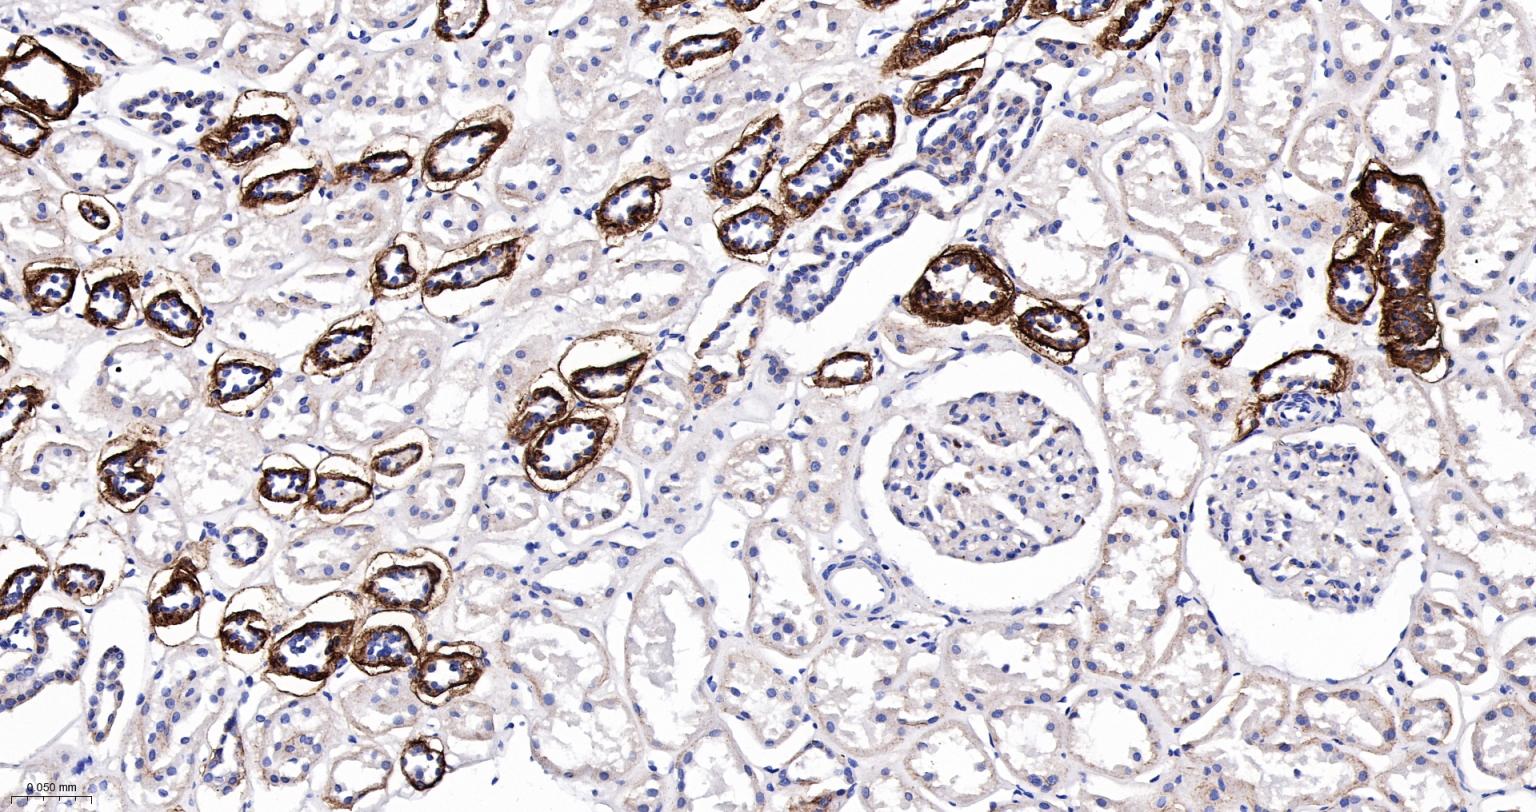
核突触蛋白-α重组兔单抗

核突触蛋白-α重组兔单抗
Rrmab?兔单抗

货号:bsm-54277R
产品详情
相关标记
相关产品
相关文献
常见问题
概述
产品编号
bsm-54277R
产品类型
重组兔单抗、帕金森相关抗体、mIHC精品抗体
英文名称
Alpha Synuclein Recombinant Rabbit mAb
中文名称
核突触蛋白-α重组兔单抗
英文别名
NACP; PARK1; PARK4; PD1; alpha-Syn; alphaSYN; SYUA_HUMAN; SNCA; Non-A beta component of AD amyloid; Non-A4 component of amyloid precursor (NACP); SYUA_MOUSE; Syn; SYUA_RAT;
抗体来源
Rabbit
免疫原
A synthesized peptide derived from human alpha Synuclein: 1-140
亚型
IgG
性状
Liquid
纯化方法
affinity purified by Protein A
克隆类型
Recombinant
克隆号
3H12
理论分子量
14 kDa
浓度
1mg/ml
储存液
0.01M TBS (pH7.4) with 1% BSA, 0.02% Proclin300 and 50% Glycerol.
研究领域
SWISS
Gene ID
保存条件
Shipped at 4℃. Store at -20℃ for one year. Avoid repeated freeze/thaw cycles.
注意事项
This product as supplied is intended for research use only, not for use in human, therapeutic or diagnostic applications.
数据库链接
产品介绍
Synuclein 包括α-Synuclein,β-Synuclein 和γ-Synuclein 是神经细胞中富含的前突触蛋白。α-Synuclein,Alzheimer’(AD)病淀粉样蛋白沉积的成份之一,集中分布在神经细胞的包体和突触。在帕金森病人中发现有α-Synuclein的变异型,而γ-Synuclein与轴突病理学有关。
此抗体将为Lewy小体痴呆症、Parkinson症、AD和其它一些神经性疾病提供有用的病理诊断。
此抗体将为Lewy小体痴呆症、Parkinson症、AD和其它一些神经性疾病提供有用的病理诊断。
背景资料
Alpha-synuclein is a member of the synuclein family, which also includes beta- and gamma-synuclein. Synucleins are abundantly expressed in the brain and alpha- and beta-synuclein inhibit phospholipase D2 selectively. SNCA may serve to integrate presynaptic signaling and membrane trafficking. Defects in SNCA have been implicated in the pathogenesis of Parkinson disease. SNCA peptides are a major component of amyloid plaques in the brains of patients with Alzheimer's disease. Alternatively spliced transcripts encoding different isoforms have been identified for this gene. [provided by RefSeq, Feb 2016].

产品应用
| 应用 | 已检合格种属 | 预测种属 | 推荐稀释比例 |
|---|---|---|---|
| WB | Human | Rat | 1:1000-2000 |
| IHC-P | Human, Rat | 1:200-800 | |
| IHC-F | Human, Rat | 1:200-800 | |
| IF | Human, Rat | 1:200-800 | |
| Flow-Cyt | Human | Rat | 1:50-100 |
| ICC/IF | Human | Rat | 1:50-200 |
交叉反应
交叉反应: Human, Rat
相关产品
暂无相关产品
靶标
基因名
SNCA
蛋白名
alpha-synuclein
亚基
Soluble monomer which can form filamentous aggregates. Interacts with UCHL1 (By similarity). Interacts with phospholipase D and histones.
Subcellular Location : Cytoplasm. Membrane. Nucleus. Cell junction, synapse. Note=Membrane-bound in dopaminergic neurons.
亚细胞定位
Cytoplasm. Membrane. Nucleus. Cell junction, synapse. Note=Membrane-bound in dopaminergic neurons.
组织特异性
Expressed principally in brain but is also expressed in low concentrations in all tissues examined except in liver. Concentrated in presynaptic nerve terminals.
翻译后修饰
Phosphorylated, predominantly on serine residues. Phosphorylation by CK1 appears to occur on residues distinct from the residue phosphorylated by other kinases. Phosphorylation of Ser-129 is selective and extensive in synucleinopathy lesions. In vitro, phosphorylation at Ser-129 promoted insoluble fibril formation. Phosphorylated on Tyr-125 by a PTK2B-dependent pathway upon osmotic stress.
Hallmark lesions of neurodegenerative synucleinopathies contain alpha-synuclein that is modified by nitration of tyrosine residues and possibly by dityrosine cross-linking to generated stable oligomers.
Ubiquitinated. The predominant conjugate is the diubiquitinated form (By similarity).
Acetylation at Met-1 seems to be important for proper folding and native oligomeric structure.
Hallmark lesions of neurodegenerative synucleinopathies contain alpha-synuclein that is modified by nitration of tyrosine residues and possibly by dityrosine cross-linking to generated stable oligomers.
Ubiquitinated. The predominant conjugate is the diubiquitinated form (By similarity).
Acetylation at Met-1 seems to be important for proper folding and native oligomeric structure.
疾病
Note=Genetic alterations of SNCA resulting in aberrant polymerization into fibrils, are associated with several neurodegenerative diseases (synucleinopathies). SNCA fibrillar aggregates represent the major non A-beta component of Alzheimer disease amyloid plaque, and a major component of Lewy body inclusions. They are also found within Lewy body (LB)-like intraneuronal inclusions, glial inclusions and axonal spheroids in neurodegeneration with brain iron accumulation type 1.
Parkinson disease 1 (PARK1) [MIM:168601]: A complex neurodegenerative disorder characterized by bradykinesia, resting tremor, muscular rigidity and postural instability. Additional features are characteristic postural abnormalities, dysautonomia, dystonic cramps, and dementia. The pathology of Parkinson disease involves the loss of dopaminergic neurons in the substantia nigra and the presence of Lewy bodies (intraneuronal accumulations of aggregated proteins), in surviving neurons in various areas of the brain. The disease is progressive and usually manifests after the age of 50 years, although early-onset cases (before 50 years) are known. The majority of the cases are sporadic suggesting a multifactorial etiology based on environmental and genetic factors. However, some patients present with a positive family history for the disease. Familial forms of the disease usually begin at earlier ages and are associated with atypical clinical features. Note=The disease is caused by mutations affecting the gene represented in this entry. [DISEASE] Parkinson disease 4 (PARK4) [MIM:605543]: A complex neurodegenerative disorder with manifestations ranging from typical Parkinson disease to dementia with Lewy bodies. Clinical features include parkinsonian symptoms (resting tremor, rigidity, postural instability and bradykinesia), dementia, diffuse Lewy body pathology, autonomic dysfunction, hallucinations and paranoia. Note=The disease is caused by mutations affecting the gene represented in this entry.
Dementia Lewy body (DLB) [MIM:127750]: A neurodegenerative disorder characterized by mental impairment leading to dementia, parkinsonism, fluctuating cognitive function, visual hallucinations, falls, syncopal episodes, and sensitivity to neuroleptic medication. Brainstem or cortical intraneuronal accumulations of aggregated proteins (Lewy bodies) are the only essential pathologic features. Patients may also have hippocampal and neocortical senile plaques, sometimes in sufficient number to fulfill the diagnostic criteria for Alzheimer disease. Note=The disease is caused by mutations affecting the gene represented in this entry.
Parkinson disease 1 (PARK1) [MIM:168601]: A complex neurodegenerative disorder characterized by bradykinesia, resting tremor, muscular rigidity and postural instability. Additional features are characteristic postural abnormalities, dysautonomia, dystonic cramps, and dementia. The pathology of Parkinson disease involves the loss of dopaminergic neurons in the substantia nigra and the presence of Lewy bodies (intraneuronal accumulations of aggregated proteins), in surviving neurons in various areas of the brain. The disease is progressive and usually manifests after the age of 50 years, although early-onset cases (before 50 years) are known. The majority of the cases are sporadic suggesting a multifactorial etiology based on environmental and genetic factors. However, some patients present with a positive family history for the disease. Familial forms of the disease usually begin at earlier ages and are associated with atypical clinical features. Note=The disease is caused by mutations affecting the gene represented in this entry. [DISEASE] Parkinson disease 4 (PARK4) [MIM:605543]: A complex neurodegenerative disorder with manifestations ranging from typical Parkinson disease to dementia with Lewy bodies. Clinical features include parkinsonian symptoms (resting tremor, rigidity, postural instability and bradykinesia), dementia, diffuse Lewy body pathology, autonomic dysfunction, hallucinations and paranoia. Note=The disease is caused by mutations affecting the gene represented in this entry.
Dementia Lewy body (DLB) [MIM:127750]: A neurodegenerative disorder characterized by mental impairment leading to dementia, parkinsonism, fluctuating cognitive function, visual hallucinations, falls, syncopal episodes, and sensitivity to neuroleptic medication. Brainstem or cortical intraneuronal accumulations of aggregated proteins (Lewy bodies) are the only essential pathologic features. Patients may also have hippocampal and neocortical senile plaques, sometimes in sufficient number to fulfill the diagnostic criteria for Alzheimer disease. Note=The disease is caused by mutations affecting the gene represented in this entry.
相似性
Belongs to the synuclein family.
功能
May be involved in the regulation of dopamine release and transport. Induces fibrillization of microtubule-associated protein tau. Reduces neuronal responsiveness to various apoptotic stimuli, leading to a decreased caspase-3 activation.
标记抗体
暂无标记数据
同靶标产品
暂无同靶标产品
相关文献
提示: 发表研究结果有使用 bsm-54277R 时请让我们知道,以便我们可以引用参考文章。作为回馈,资料提供者将获得我们送上的小礼品。
具体参考文献:bsm-54277R 被引用于2文献中
暂无相关文献
常见问题
暂无常见问题